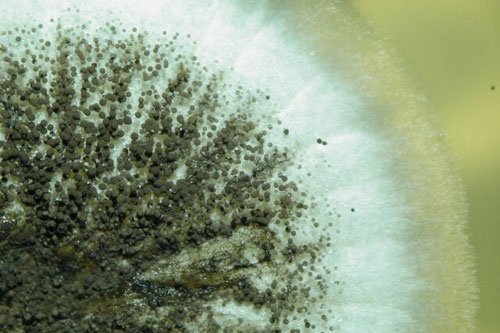

Pilzsystematik und Taxonomie
Arbeitsgruppenleitung: Martin Kirchmair
Team:
- Georg Walch (PhD candidate)
- Alex Schwarz (PhD candidate)
- Katharina Russ (PhD candidate)
- Bettina Schneidhofer (TA)
Bachelor- und Masterstudierende:
- Eldina Samardzic, BSc
- Erik Doubrava, BSc

Forschungsgebiet
Unsere Arbeitsgruppe ist auf die Taxonomie von Pilzen spezialisiert. Wir beschäftigen uns intensiv mit der wissenschaftlichen Beschreibung und Klassifizierung neuer Pilzarten.
Neben der Grundlagenforschung legen wir großen Wert auf die praktische Anwendung unseres Fachwissens. So analysieren wir beispielsweise Umweltproben, insbesondere aus Innenräumen, um Schimmelpilze, Bakterien und holzzerstörende Pilze zu identifizieren und zu bewerten. Diese Arbeit ist entscheidend für die Beurteilung der mikrobiellen Kontamination und die Festlegung geeigneter Sanierungsmaßnahmen.
Ein weiterer Schwerpunkt liegt auf der Optimierung von Arbeitsabläufen in der Umweltanalytik. Wir entwickeln und verfeinern Methoden, um mikrobiologische Untersuchungen effizienter, präziser und benutzerfreundlicher zu gestalten
Aktuelle Projekte
- Identification of CAZymes from Serpula lacrymans associated bacteria and quantification of their expression with focus on lignin and cellulose enzymes